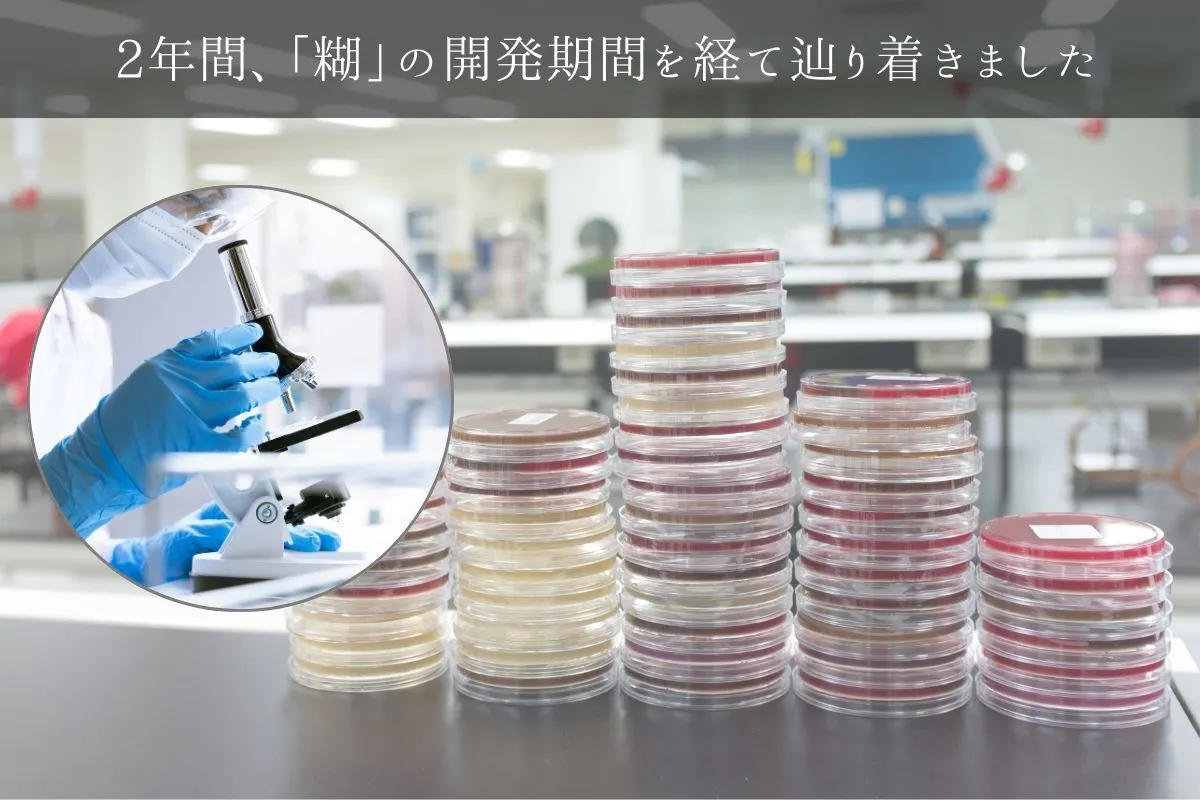

ウチハクの新しい挑戦を紹介させていただきます。
こんにちは、村田金箔所属ウチハクプロジェクトリーダーの南 博章です。
まずはじめにお礼を言わせて下さい。
今のウチハクが誕生できたのは、みなさんの温かい応援とサポートのおかげです!
どんな小さなアイデアも、みなさんの後押しやアドバイスがあってこそ形になり、ここまで来ることができました。本当に感謝しています!
みなさんが支えてくれたからこそ、ウチハクを世に送り出すことができたし、新しい可能性にもチャレンジすることができています。
ありがとうございます。


毎日の“輝き”をつくる箔の老舗企業が、いよいよ表舞台に登場!160年の技術が集結!
2025年に創業160年を迎える村田金箔株式会社が、クラウドファンディングに挑戦します。「村田金箔」の名前は聞いたことなくっても箔押しされた製品は目にした事があると思います。
例えば、ドラッグストアにある薬のパッケージ。百貨店で売っている化粧品や、贈答用のお菓子のパッケージ。お酒のラベルから釣り具のルアー。書店に並ぶ本や雑誌の表紙の部分からトレーディングカードやおまけのシールに至るまで・・・
実は、日常で目にする「キラッ」と光るアレ。全部「箔」なんです。その多くは当社で箔の製造を行い、それぞれの加工先(箔押し屋さんや印刷会社さん)へ供給しています。
そんな当社は創業以来、伝統を守りつつも技術革新を重ね、現在では箔の厚み、均一性、発色など、細部にまでこだわった製品を提供し「見た目の美しさ」だけでなく、耐久性や色の豊富でも高い評価をいただき、業界トップシェアをいただけるようになりました。
箔の輝きを人肌に。今までにない、人肌に使えるウチハクtatoo stickerに挑戦します
そんな当社が挑戦するは「お肌に貼れるウチハク専用糊ステッカー」です。これが完成すれば、日本中の様々なハレの日が、今まで以上に美しく、輝きを増すこと間違いなしです。
たとえば、スポーツ観戦や推し活、その他の特別な日に、このウチハクtatoo stickerシリーズを使えば、箔押しの輝きを人肌に簡単に楽しむことができ、より一層思い出深い、輝く日になると確信しています。


使い方はとっても簡単。届いたその日からウチハクを人肌に。勿論、安心・安全の日本製です。
ウチハクtatoo stickerは、ウチハクを人肌に簡単に箔押しできる便利なシールです。使い方はとてもシンプルで、貼って、はがして、ウチハクをそのままお肌に貼るだけで美しい仕上がりが得られます。
ウチハクだけでなく、ウチハクtatoo stickerも全て日本製、品質にもこだわった商品だから、安心してお使いいただけます。
肌に直接使用するものだからこそ、安心・安全を重視し、日本の高い技術力で作られた信頼できる製品をお届けしています。
安全性を重視して開発した商品だから、お子様でも安心してお使いいただけます。
※ウチハクtatoo stickerはISO10993 に基づく生物学的安全性を検証した商品です



糊研究の試行錯誤の結果、最適解を見つけることができました。
人肌に使用することのできる糊の開発は非常に困難なもので、肌に優しく、かつしっかりと接着。更に、その上からウチハクを使用するという条件を満たすために、試行錯誤を繰り返しました。
1年と6ヶ月という長い開発期間を費やし、様々な素材や成分を試し続け、ようやく満足のいく答えを見つけることができました。
完成すれば、ウチハクは新たなステージへと進み、多くの人々の特別な瞬間をより一層輝かせる存在となれると信じています。

商品紹介「ウチハクtatoo sticker」はseat(シートタイプ)と flakes(フレークスタイプ)の2種類があります
人肌に使えるウチハクtatoo stickerは「ウチハク専用の糊ステッカー」です。
貼った上からウチハクで箔色を付けて楽しんでいただけます。(ステッカー自体は無色透明なので透明ホログラムも使用できます)
自由にカットして楽しめるseatタイプと形になっているflakesタイプの2種類をご用意しています。
ご自身の用途、お好みに合わせて使い分けていただけます。
※剥がしたい時はウチハクtatoo stickerの端部分を持ってそのままゆっくりと剥がして下さい(絆創膏を剥がすようなイメージです)

お手持ちのウチハクをそのまま肌用にもお使いいただけます
ウチハクtatoo stickerシリーズを楽しんでいただくために、新しくウチハクを購入する必要はございません。
現在お手持ちのウチハクを、そのまま問題なくお使いいただけます。
既にウチハクをご愛用いただいているお客様であれば、追加のコストをかけることなく、新商品をお楽しみいただける点が大きなメリットです。
新たに商品を買い足しをすることなく、新しい表現にチャレンジしていただけます。
お手持ちのウチハクを最大限に活かしながら、ウチハクtatoo stickerを楽しんでいただけます!

「ウチハク」を初めて聞いた方はこちらもお読みください
以上が新商品、ウチハクtatoo stickerシリーズの概要紹介でした。
ここで、ウチハクを「初めて聞いた、知った。」という方は是非、こちらもお読みください。
ウチハクは糊の粘着を利用してお家で簡単に箔押しができる専用箔です。
開発したのは2025年に創業160年を迎える老舗箔メーカー村田金箔グループです。
先述した通りこの度、当社は人肌に使用できるウチハク専用糊の開発に成功しました。
人肌にもウチハクをお楽しみいただくこともできますが、文房具や画材としてもお楽しみいただくことができます。

ウチハクtatoo stickerシリーズリターンのご紹介
今回リターンは大きく分けて3種類ご用意させていただきました。
①既にウチハクをお持ちの方向けのリターン
リターン価格:1,800円
リターン価格:4,300円
②ウチハクを初めて知った方向けのリターン
リターン価格:17,800円
リターン価格:14,400円
③すでにウチハクは持っているが、この機会に箔色を増やしたい方向けのリターン
リターン価格:8,700円
リターン価格:4,300円
ぜひ、ご自身の楽しみたいコースをお選びいただき、お肌への箔押しをお楽しみ下さい。
<使用上の注意>
お肌に異常が生じていないかよく注意して使用してください。
商品がお肌に合わない時やはれもの、しっしん等、異常のある部位にはお使いにならないでください。
油分の多い箇所やメイクの上にはウチハクtatoo stickerがうまく貼れない場合がございますので、密着感をお試しになってからお楽しみ下さい。
<保管及び取扱上の注意>
乳幼児の手の届かないところに保管してください。
直射日光のあたる場所には保管しないでください。
開封後はなるべくお早めにご使用ください。
クラウドファンディングのスケジュール
2024年11月24日(日)・クラウドファンディング開始
2025年1月5日(月)・クラウドファンディング終了
<製品お届けまでのスケジュール>
2025年1月・完成品チェック、製品の量産開始
2025年2月・製品の検品と出荷準備
2025年3月上旬・製品を購入者に順次配送
Q&A
Q1:プロジェクトに支援する際の支払い方法を教えてください。
A:こちらをご確認ください。
Q2:海外からの支援は可能ですか? Is it possible to support from overseas?
A: 発送は国内のみに限らせていただきます。 Not all products are available for shipping internationally.
Q3:リターンの表記は税込みですか?
A: はい、記載されている商品は全て税込み・送料込みの値段です。
Q4:一人何コースまで買えますか?
A: 購入制限は特に設けておりません。複数のコースが支援可能です。同時に決済をされる場合は、リターン選択時に「続けて他のリターンを選択する」よりお選びください。
また1つのリターンコースを複数個支援する場合は、支援時に数量を選択してください。(ただし限定数が設定されているものは複数個支援ができません)
最新の活動報告
もっと見る
ウチハクtatoo sticker×ウチハク透明ホログラム
2024/11/26 13:00ウチハク透明ホログラムでお肌に箔押しするとこんな感じ※糊は無色透明なので透過されます#campfire#ウチハク#箔押し#推し活#レイヤー#ハレの日ウチハクtatoo stickerは無色透明その上に透明ホログラムを貼ってはがすとお肌の色が透過されます もっと見る




コメント
もっと見る